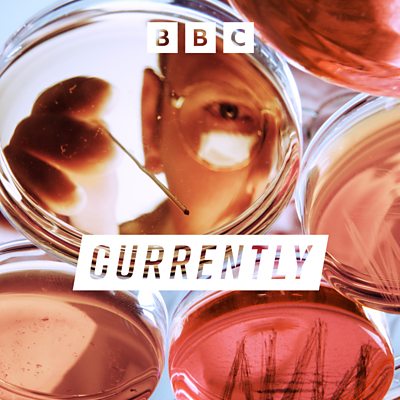

Episode details
Available for over a year
What is going on with US science? Science Journalist Roland Pease asks whether the rounds of cuts, reorganisations and political strong-arming can be weathered, and how they will likely affect us all. 80 years after Vannevar Bush proposed what became the pact between government and universities that led to decades of global scientific dominance, is the edifice being toppled? Bush’s report “Science, The Endless Frontier†led to the unwritten pact between university scientists and government funding that underpinned US leadership until now. “Trust us with the money, we’ll give you the global scientific advantageâ€. Today, US scientists fear the Trump administration is ripping up that agreement. Mandating what and what can’t be studied, who can study it, and re-defining expertise, government funded science in the US is being withered. The specialist agencies are either being closed down or defunded to the extent that many tens of thousands of government scientists are already unemployed. Multi-year experiments are being closed down uncompleted. Top universities are besieged by mandates on who and how they hire, tied to their future funding. Data streams that benefit researchers around the globe are being switched off. Even definitions of what counts as evidence are being re-drafted. Science is a complex, interwoven and international activity. The administration's declared aim is "Restoring Gold Standard Science", but scientific bodies fear its actions will cede global leadership to China, and that the whole world may be poorer. Can the coming storm be weathered, even if we can no longer predict it? Produced by Alex Mansfield Written and Presented by Roland Pease
Programme Website